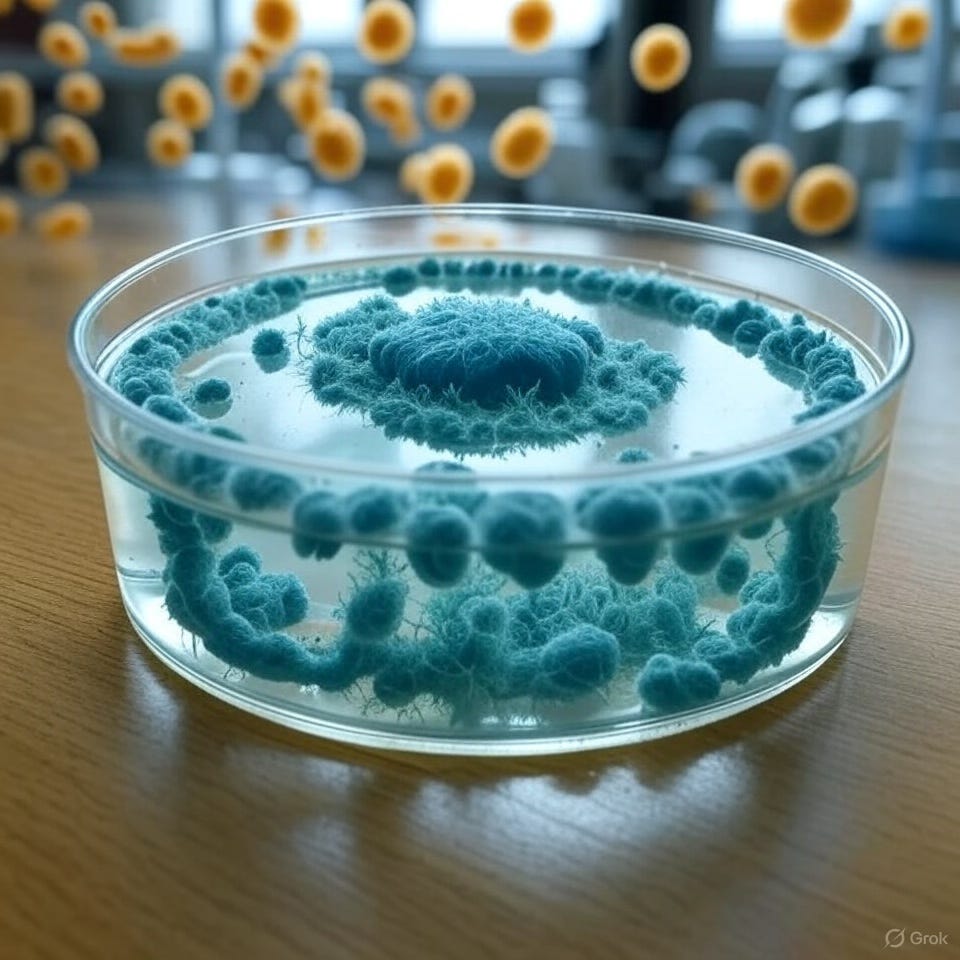

Information, Intelligence, Creativity, and Asymmetric Learning: Why Curiosity Fuels Pharma’s Edge
Have you ever found yourself buried in a Phase II dataset, staring at numbers that just won’t tell you anything? That’s pharma R&D - drowning in information but desperate for insight. We’ve clinical readouts, genomic maps, patient registries, and market forecasts flooding in like rain in Manchester. But data alone doesn’t spark breakthroughs. It takes intelligence - human intelligence, laced with creativity - to turn raw numbers into life-changing therapies. To leap ahead? That’s where asymmetric learning, powered by curiosity, gives an edge. Let’s look at why this trio - information, intelligence, creativity - and a curious mindset are pharma’s asymmetric advantage.
Information: The Raw Deluge
Information is our starting point: the raw, unfiltered data of the pharma world. It’s trial endpoints, molecular structures and substructures, adverse event logs, or payer demands neatly lined up in McK spreadsheets and slide decks. Picture efficacy data from 10,000 patients - factual, quantifiable, and a junior-level slog. We’re pros at aggregating it/ hoarding it - high-throughput screens, AI sifting chemical libraries, real-world evidence from wearables. But as I’ve written about before (that recent post on the Predict, Pick, Plan model’s flops), information is just noise without a spark. It’s the “what,” sitting there, begging to be questioned.
Intelligence: Human Minds Making Sense
Intelligence is where the grind meets the “aha.” It’s the ability to wrestle with data, spot patterns, and ask why. Specifically, human intelligence - that uniquely messy, intuitive knack for connecting dots machines can’t yet touch. It’s the clinician who flags an outlier in a trial, the scientist who links a molecule’s odd pocket to an unmet need, or the team pivoting a drug’s indication after a failed study endpoint. Intelligence isn’t just processing; it’s reasoning, contextualizing, and deciding what’s next. But in pharma’s high-stakes game, where R&D costs can hit $2.6 billion per drug on average, intelligence alone isn’t enough.
Creativity: The X-Factor
Here’s where creativity enters the team meeting. Human intelligence shines brightest when paired with creative leaps - those bold, sometimes wild ideas that defy linear thinking. Creativity is the researcher who wonders, “What if we test this drug in a completely different disease?” It’s the spark behind penicillin’s accidental discovery or thalidomide’s pivot from morning sickness disaster to multiple myeloma star. As I’ve noted before, serendipity drives at least 6% of today’s marketed drugs (‘at least’ because these are the ones companies have admitted) - happy accidents born from creative minds asking, “What else could this mean?” Creativity isn’t just flair; it’s the courage to explore uncharted paths, to nurture “planned serendipity” where preparation meets the unexpected.
Asymmetric Learning: Curiosity’s Uneven Edge
Now, tie intelligence and creativity to asymmetric learning, and you’ve got a game-changing approach to R&D. Asymmetric learning isn’t about plodding from proof-of-concept to approval like a checklist (a trap I’ve called out for killing innovation). It’s about learning faster, deeper, and more creatively than competitors, creating high-reward, proprietary insights others can’t match. Think of a team using AI to spot a novel biomarker and creatively hypothesizing its link to a rare disease. Or, as Dr. Andrew Robertson at Takeda might ask, “Why this roadblock?” - then creatively reimagining the trial design. It’s high-upside bets with minimal downside, driven by curiosity.
Take Opdivo vs. Keytruda: by 2019, $25.7 billion vs. $23.5 billion in cumulative sales, despite Keytruda’s extra $3 billion R&D tab. Why? Creative, human-driven decisions - exploratory sprints, not rigid TPPs or eNPV’s “fake-accuracy” (or fakeuracy, as I’ve dubbed it). Those linear models? Inevitably wrong, path-specific at best, averaged mush at worst. Asymmetric learning, fueled by curious, creative humans, flips the script: iterative “if, then” pivots, multidisciplinary teams ideating across silos. That Keytruda went on to win is also an asymmetric learning case study - saying ‘yes’ to new indications, testing biomarkers and more.
Why This Matters Now
In pharma, where success rates hover at 10%, and may be in decline, information without intelligence is a trap, and intelligence without creativity is just keeping up. Add asymmetric learning, and you’re not just innovating - you’re outpacing. Curiosity - human, creative curiosity - ties it all together. It’s what enables teams at Novartis to run “exploration sprints” or identify bottlenecks to unlock new patient benefits.
Building the Edge
So, how do we do it at IDEA? Ditch linear pipelines for exploratory bursts. Integrate diverse data - clinical, genomic, human and behavioral - and let creative humans ask bold “what ifs.” Use AI to amplify, not replace, human ingenuity. And yes, measure curiosity in reviews - reward the questioners.
At IDEA, we’re all about turning data deluges into delightfully uneven returns. Curiosity, creativity, and human intelligence aren’t just nice-to-haves - they’re how we work.